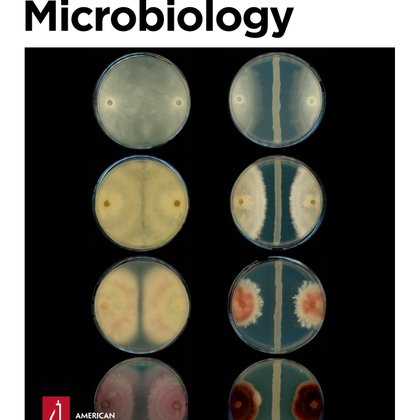
Tweet card summary image

The Twinkle Factory
@TwinkleFactory1
Followers
73
Following
117
Media
1
Statuses
90
At The Twinkle Factory, we enjoy colorful, fluorescent, blinking, life sciences! Stain Different. Tag FAST.
Paris, France
Joined September 2020
Save the date! For the first time since 2015, the annual conference of the International Chemical Biology Society comes back to Europe and joins forces with the European Chemical Biology Symposium, to organize #ChemBioParis2025, in the heart of the City of Light. Oct 6-9, 2025
0
12
41
The Centre for Targeted Protein Degradation @UoDCeTPD @alessiociulli is #recruiting. Join the team! 💪 https://t.co/lFYdHlRtNI
#biophysics
https://t.co/rJe96kEr9o
#medchem #chemjobs
https://t.co/hIE3p8ToYk
#chemicalproteomics
0
10
24
Very happy to share our latest work on @angew_chem Great collaboration with Ewing @AndrewEwing11 and Peng@NJU. Well done Kele @kelechen_chem Electrochemical Monitoring of Real‐Time Vesicle Dynamics Induced by Tau in a Confined Nanopipette -
onlinelibrary.wiley.com
We developed a synapse-mimicking nanopipette method to electrochemically monitor single vesicle dynamics induced by lipid-tau interactions. Characteristic ionic current oscillations have been used...
0
2
24
Nanopore Weekly Meeting on 15 July, 2024 at 14.00 (CEST). We will have Professor Mihail Barboiu presenting Artificial Water Channels. Zoom Link: https://t.co/VUwQKjaeGO Meeting-ID: 84644647831 #NanoporeElectrochemistry
0
2
5
Conditional PROTAC: Recent Strategies for Modulating Targeted Protein Degradation - Yim - ChemMedChem - Wiley Online Library
chemistry-europe.onlinelibrary.wiley.com
To overcome the limitations of conventional PROTACs, conditional PROTACs have been developed. This review highlights recent strategies for modulating targeted protein degradation in spatio-, tempor...
0
0
0
Conditional PROTAC: Recent Strategies for Modulating Targeted Protein Degradation - ChemMedChem - Wiley Online Library
chemistry-europe.onlinelibrary.wiley.com
To overcome the limitations of conventional PROTACs, conditional PROTACs have been developed. This review highlights recent strategies for modulating targeted protein degradation in spatio-, tempor...
1
6
31
It was great to discuss with experts on fluorescent biosensors Arnaud Gautier, Robert Campbell @Campbell_FPs and @joachimgoedhart after mini-symposium "Illuminating life with advanced fluorescent probes". Thanks Arnaud for the invitation!
0
3
40
Read this #preprint on @researchsquare: Synthetic protein degradation circuits using programmable cleavage and ligation by Sortase A https://t.co/7aCdvsTnal
#FAST #splitFAST #bioPROTAC #PROTAC
researchsquare.com
BioPROTACs are heterobifunctional proteins designed for targeted protein degradation (TPD). They are useful not only for probing protein functions but also offer a therapeutic avenue for modulating...
0
0
1
A guide to genetically-encoded redox biosensors: state of the art and ...
0
0
0
Teaching old dogs new tricks: genetic engineering methanogens | Applied and Environmental Microbiology
journals.asm.org
The discovery of methane- (CH4-) producing microbes with DNA sequences distinct from bacterial DNA led to the establishment of Archaea as a new domain of life (1). Methanogens, which exhibit unique...
0
0
0
Mandatory!
Join us for a minisymposium on "Illuminating life with advanced fluorescent probes" - July 11, 2024 in Paris - organized by Arnaud Gautier and @LinaElHajji1
0
0
2
🌈 pushing #FAST and #splitFAST towards near infrared!🍭 A tunable and versatile chemogenetic near infrared fluorescent reporter
biorxiv.org
Near-infrared (NIR) fluorescent reporters provide additional colors for highly multiplexed imaging of cells and organisms, and enable imaging with less toxic light and higher contrast and depth....
0
0
0
🌈 multiplexing FAST and splitFAST with FLIM 🍭 Multiplexed in vivo imaging with fluorescence lifetime modulating tags
biorxiv.org
Fluorescence lifetime imaging opens new dimensions for highly multiplexed imaging in live cells and organisms using differences in fluorescence lifetime to distinguish spectrally identical fluoresc...
0
0
0
🌈 FAST and splitFAST powered 🍭 Simultaneous detection of membrane contact dynamics and associated Ca2+ signals by reversible chemogenetic reporters
biorxiv.org
Membrane contact sites (MCSs) are hubs allowing various cell organelles to coordinate their activities. The dynamic nature of these sites and their small size hinder analysis by current imaging...
0
0
0
🌈 FAST and splitFAST powered 🍭 Human MX1 orchestrates the cytoplasmic sequestration of neo-synthesized influenza A virus vRNPs
biorxiv.org
Interferon-inducible Myxovirus resistance 1 (MX1) proteins are well-known to restrict influenza A virus (IAV) at early stages during viral replication, impairing the viral transcription/replication...
0
2
3
🌈 FAST & splitFAST powered 🍭 Cell-surface receptor-mediated regulation of synaptic organelle distribution controls dendritic spine maturation
biorxiv.org
The spine apparatus (SA), an endoplasmic reticulum-related organelle present in a subset of mature dendritic spines, plays a key role in postsynaptic development and has been implicated in various...
0
0
1
Just arrived in Munich! Excited to hear great talks and present our latest research at the #GDCh Frontiers in Medicinal Chemistry Symposium! https://t.co/Us815bTdFU
2
2
31
It was great to start the school on #fluorescence #markers for advanced #microscopy #fluorescenceleshouches with a fundametal talk by Ludovic Jillien.
0
3
33
🌈 and fluorogenic molecular glues for CATCHFIRE are available at https://t.co/rvaUhILm2U 🍭
🌈plasmids now available at @addgene 🍭 https://t.co/HIWFn1Gcru
0
0
1
🌈🌈 "controlling, imaging and sensing protein proximity" all together! Congrats! 🍭🍭 #CIP #proteindimerizer
Bottone, S., Joliot, O., Cakil, Z.V. et al. A fluorogenic chemically induced dimerization technology for controlling, imaging and sensing protein proximity. Nat Methods (2023).
0
0
0